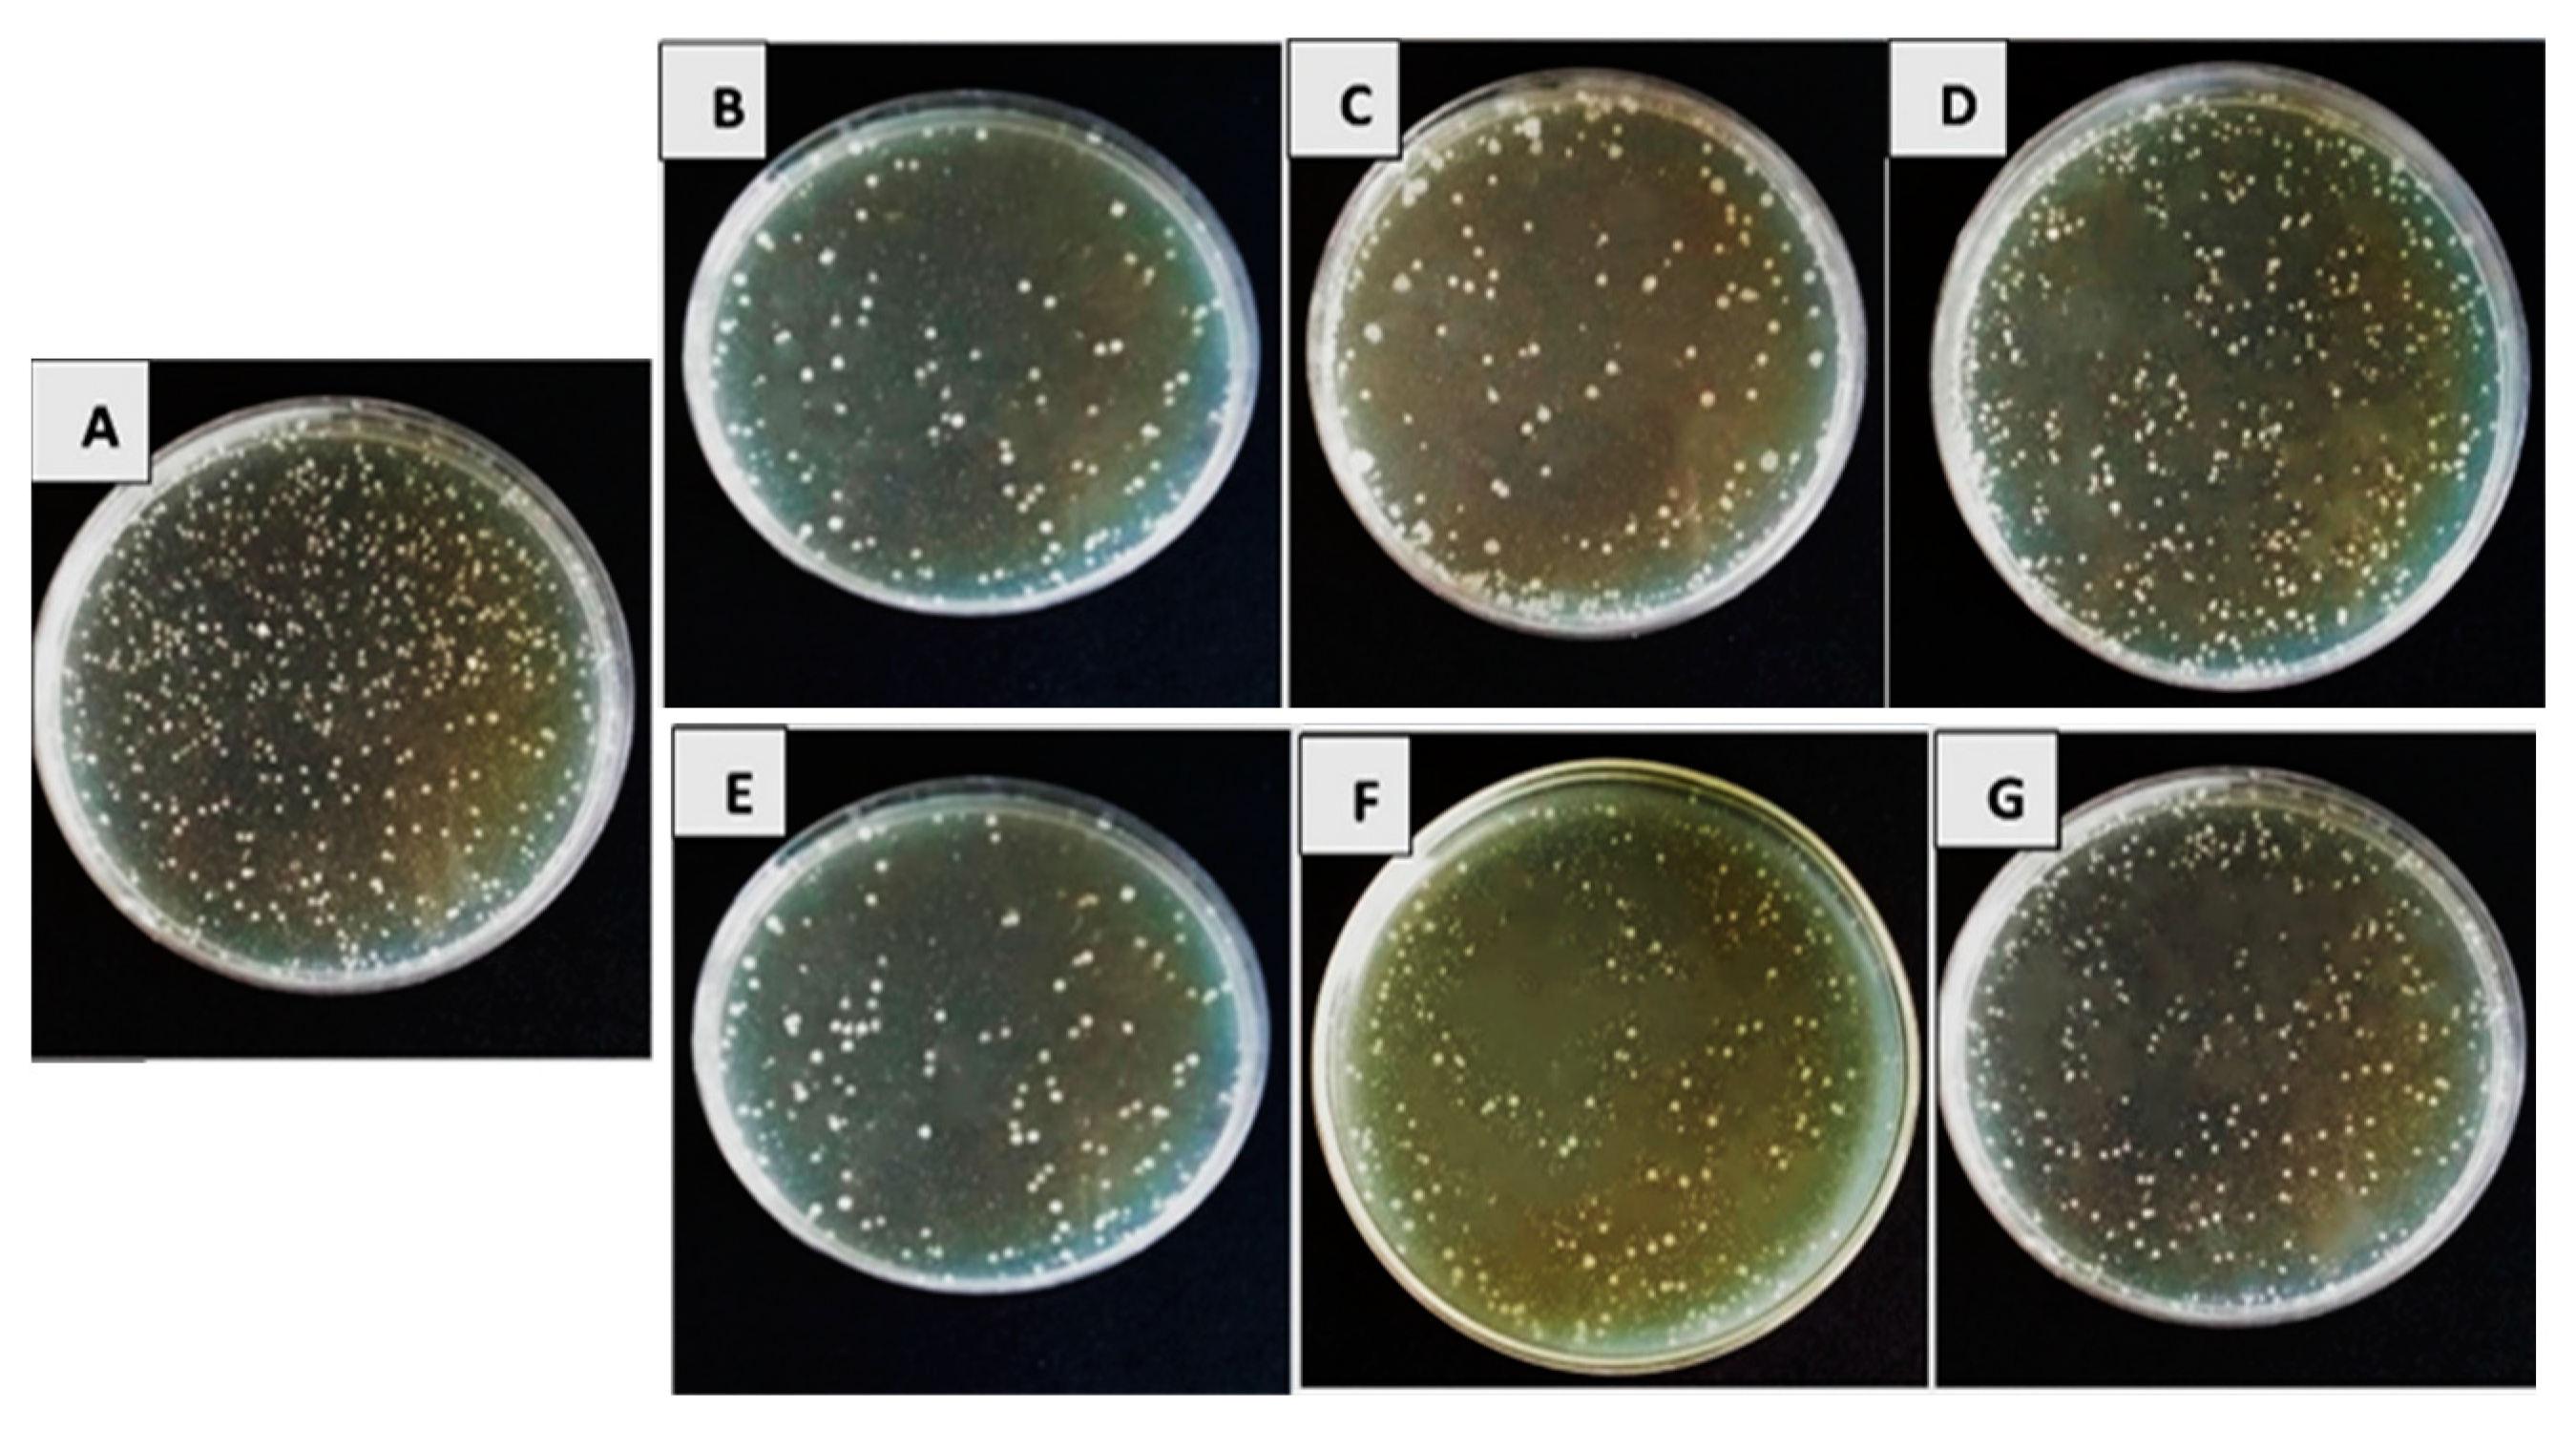
Biology 13 00369 g002

Biological Control of Tomato Bacterial Leaf Spots and Its Impact on Some Antioxidant Enzymes, Phenolic Compounds, and Pigment Content
Abstract
:Simple Summary
Abstract
1. Introduction
2. Materials and Methods
2.1. Inoculum of the Pathogenic Bacteria
2.2. Bioagent Culture Filtrates
2.3. In Vitro Assays
2.4. In Vivo Assays
2.5. Antioxidant Enzymes Activity
2.5.1. Phosphate Buffer Preparation and Enzyme Extraction
2.5.2. Peroxidase Activity
2.5.3. Polyphenol Oxidase Activity
2.5.4. Chitinase Activity
2.6. Determination of Phenolic Compounds
2.7. Photosynthetic Pigment Analysis
2.8. Statistical Analysis
3. Results
3.1. In Vitro Efficacy of Bioagents’ Filtrates on Bacterial Pathogens’ Growth Reduction
3.2. In Vivo Assessment
3.2.1. Efficacy of Bioagents’ Culture Filtrates on Leaf Spot and Speck Diseases in Tomato Plants
3.2.2. In Vivo Changes in Phenolic Compounds
3.2.3. In Vivo Changes in Antioxidant Enzymes
3.2.4. Changes in Chlorophyll a, Chlorophyll b and Carotenoids
4. Discussion
5. Conclusions
Author Contributions
Funding
Institutional Review Board Statement
Informed Consent Statement
Data Availability Statement
Acknowledgments
Conflicts of Interest
References
- FAO. Crops and Livestock Products. Available online: http://www.fao.org/FAOSTAT/en/ (accessed on 1 November 2020).
- Pohronezny, K.; Volin, R. The Effect of Bacterial Spot on Yield and Quality of Fresh Market Tomatoes1. HortScience 1983, 18, 69–70. [Google Scholar] [CrossRef]
- Perez, K.; Froikin-Gordon, J.S.; Abdourhamane, I.K.; Levasseur, V.; Alfari, A.A.; Mensah, A.; Bonsu, O.; Habsatou, B.; Assogba-Komlan, F.; Mbaye, A.A. Connecting smallholder tomato producers to improved seed in West Africa. Agric. Food Secur. 2017, 6, 42. [Google Scholar] [CrossRef]
- Raymaekers, K.; Ponet, L.; Holtappels, D.; Berckmans, B.; Cammue, B.P. Screening for novel biocontrol agents applicable in plant disease management—A review. Biol. Control 2020, 144, 104240. [Google Scholar] [CrossRef]
- Potnis, N. Harnessing Eco-Evolutionary dynamics of Xanthomonads on tomato and pepper to tackle new problems of an old disease. Annu. Rev. Phytopathol. 2021, 59, 289–310. [Google Scholar] [CrossRef]
- Savary, S.; Willocquet, L.; Pethybridge, S.J.; Esker, P.; McRoberts, N.; Nelson, A. The global burden of pathogens and pests on major food crops. Nat. Ecol. Evol. 2019, 3, 430–439. [Google Scholar] [CrossRef] [PubMed]
- Wai, K.P.P.; Siddique, M.I.; Mo, H.-S.; Yoo, H.J.; Byeon, S.-E.; Jegal, Y.; Mekuriaw, A.A.; Kim, B.-S. Pathotypes of bacterial spot pathogen infecting Capsicum peppers in Korea. Plant Pathol. J. 2015, 31, 428. [Google Scholar] [CrossRef]
- Jones, J.B.; Zitter, T.A.; Momol, T.M.; Miller, S.A. Compendium of Tomato Diseases and Pests; APS Press: College Park, MD, USA, 2014. [Google Scholar]
- Farias, G.A.; Olmedilla, A.; Gallegos, M.T. Visualization and characterization of Pseudomonas syringae pv. tomato DC 3000 pellicles. Microb. Biotechnol. 2019, 12, 688–702. [Google Scholar] [CrossRef] [PubMed]
- Abrahamian, P.; Jones, J.B.; Vallad, G.E. Efficacy of copper and copper alternatives for management of bacterial spot on tomato under transplant and field production. Crop Prot. 2019, 126, 104919. [Google Scholar] [CrossRef]
- Šević, M.; Gašić, K.; Ignjatov, M.; Mijatović, M.; Prokić, A.; Obradović, A. Integration of biological and conventional treatments in control of pepper bacterial spot. Crop Prot. 2019, 119, 46–51. [Google Scholar] [CrossRef]
- Herbert, A.; Hancock, C.N.; Cox, B.; Schnabel, G.; Moreno, D.; Carvalho, R.; Jones, J.; Paret, M.; Geng, X.; Wang, H. Oxytetracycline and streptomycin resistance genes in Xanthomonas arboricola pv. pruni, the causal agent of bacterial spot in peach. Front. Microbiol. 2022, 13, 821808. [Google Scholar] [CrossRef]
- Gikas, G.D.; Parlakidis, P.; Mavropoulos, T.; Vryzas, Z. Particularities of fungicides and factors affecting their fate and removal efficacy: A review. Sustainability 2022, 14, 4056. [Google Scholar] [CrossRef]
- El-Gremi, S.M.; Draz, I.S.; Youssef, W.A.-E. Biological control of pathogens associated with kernel black point disease of wheat. Crop Prot. 2017, 91, 13–19. [Google Scholar] [CrossRef]
- Sharma, V.; Salwan, R.; Sharma, P. The comparative mechanistic aspects of Trichoderma and probiotics: Scope for future research. Physiol. Mol. Plant Pathol. 2017, 100, 84–96. [Google Scholar] [CrossRef]
- Segarra, G.; Casanova, E.; Avilés, M.; Trillas, I. Trichoderma asperellum strain T34 controls Fusarium wilt disease in tomato plants in soilless culture through competition for iron. Microb. Ecol. 2010, 59, 141–149. [Google Scholar] [CrossRef] [PubMed]
- Marzano, M.; Gallo, A.; Altomare, C. Improvement of biocontrol efficacy of Trichoderma harzianum vs. Fusarium oxysporum f. sp. lycopersici through UV-induced tolerance to fusaric acid. Biol. Control 2013, 67, 397–408. [Google Scholar]
- Thayer, P.; Stall, R. The survey of Xanthomonas vesicatoria resistance to streptomycin. Proc. Fla. State Hortic. Soc. 1962, 75, 163–165. [Google Scholar]
- Vallad, G.E.; Pernezny, K.L.; Balogh, B.; Wen, A.; Figueiredo, J.F.L.; Jones, J.B.; Momol, T.; Muchovej, R.M.; Havranek, N.; Abdallah, N. Comparison of kasugamycin to traditional bactericides for the management of bacterial spot on tomato. HortScience 2010, 45, 1834–1840. [Google Scholar] [CrossRef]
- Narayanasamy, P. Biological Management of Diseases of Crops; Springer: Berlin/Heidelberg, Germany, 2013; Volume 673. [Google Scholar]
- Dimkić, I.; Janakiev, T.; Petrović, M.; Degrassi, G.; Fira, D. Plant-associated Bacillus and Pseudomonas antimicrobial activities in plant disease suppression via biological control mechanisms—A review. Physiol. Mol. Plant Pathol. 2022, 117, 101754. [Google Scholar] [CrossRef]
- Byrne, J.; Dianese, A.; Ji, P.; Campbell, H.; Cuppels, D.; Louws, F.; Miller, S.; Jones, J.; Wilson, M. Biological control of bacterial spot of tomato under field conditions at several locations in North America. Biol. Control 2005, 32, 408–418. [Google Scholar] [CrossRef]
- Ji, P.; Campbell, H.; Kloepper, J.; Jones, J.; Suslow, T.; Wilson, M. Integrated biological control of bacterial speck and spot of tomato under field conditions using foliar biological control agents and plant growth-promoting rhizobacteria. Biol. Control 2006, 36, 358–367. [Google Scholar] [CrossRef]
- Hemlata Chauhan, H.C.; Bagyaraj, D.; Selvakumar, G.; Sundaram, S. Novel plant growth promoting rhizobacteria-prospects and potential. Appl. Soil Ecol. 2015, 95, 38–53. [Google Scholar] [CrossRef]
- Wu, B.; Wang, X.; Yang, L.; Yang, H.; Zeng, H.; Qiu, Y.; Wang, C.; Yu, J.; Li, J.; Xu, D. Effects of Bacillus amyloliquefaciens ZM9 on bacterial wilt and rhizosphere microbial communities of tobacco. Appl. Soil Ecol. 2016, 103, 1–12. [Google Scholar] [CrossRef]
- Chandrasekaran, M.; Paramasivan, M.; Chun, S.-C. Bacillus subtilis CBR05 induces Vitamin B6 biosynthesis in tomato through the de novo pathway in contributing disease resistance against Xanthomonas campestris pv. vesicatoria. Sci. Rep. 2019, 9, 6495. [Google Scholar] [CrossRef] [PubMed]
- Kavitha, R.; Umesha, S. Regulation of defense-related enzymes associated with bacterial spot resistance in tomato. Phytoparasitica 2008, 36, 144–159. [Google Scholar] [CrossRef]
- Lattanzio, V.; Lattanzio, V.M.; Cardinali, A. Role of phenolics in the resistance mechanisms of plants against fungal pathogens and insects. Phytochem. Adv. Res. 2006, 661, 23–67. [Google Scholar]
- Dicko, M.H.; Gruppen, H.; Traoré, A.S.; Voragen, A.G.; van Berkel, W.J. Phenolic compounds and related enzymes as determinants of sorghum for food use. Biotechnol. Mol. Biol. Rev. 2006, 1, 20–37. [Google Scholar]
- Umesha, S. Occurrence of bacterial canker in tomato fields of Karnataka and effect of biological seed treatment on disease incidence. Crop Prot. 2006, 25, 375–381. [Google Scholar] [CrossRef]
- Backer, R.; Rokem, J.S.; Ilangumaran, G.; Lamont, J.; Praslickova, D.; Ricci, E.; Subramanian, S.; Smith, D.L. Plant growth-promoting rhizobacteria: Context, mechanisms of action, and roadmap to commercialization of biostimulants for sustainable agriculture. Front. Plant Sci. 2018, 9, 402666. [Google Scholar] [CrossRef]
- Saini, S.; Lohani, S.; Khati, P.; Rani, V. PGPR-mediated mitigation of biotic and abiotic stress in plants. In Advanced Microbial Technology for Sustainable Agriculture and Environment; Elsevier: Amsterdam, The Netherlands, 2023; pp. 199–227. [Google Scholar]
- El-Fatah, B.E.A.; Imran, M.; Abo-Elyousr, K.A.; Mahmoud, A.F. Isolation of Pseudomonas syringae pv. Tomato strains causing bacterial speck disease of tomato and marker-based monitoring for their virulence. Mol. Biol. Rep. 2023, 50, 4917–4930. [Google Scholar] [CrossRef]
- Kyeon, M.-S.; Son, S.-H.; Noh, Y.-H.; Kim, Y.-E.; Lee, H.-I.; Cha, J.-S. Xanthomonas euvesicatoria causes bacterial spot disease on pepper plant in Korea. Plant Pathol. J. 2016, 32, 431. [Google Scholar] [CrossRef]
- Khan, Z.; Kim, S.; Jeon, Y.; Khan, H.; Son, S.; Kim, Y. A plant growth promoting rhizobacterium, Paenibacillus polymyxa strain GBR-1, suppresses root-knot nematode. Bioresour. Technol. 2008, 99, 3016–3023. [Google Scholar] [CrossRef]
- Brian, P.; Hemming, H. Gliotoxin, a fungistatic metabolic product of Trichoderma viride. Ann. Appl. Biol. 1945, 32, 214–220. [Google Scholar] [CrossRef]
- Bonilla, N.; Vida, C.; Martínez-Alonso, M.; Landa, B.B.; Gaju, N.; Cazorla, F.M.; De Vicente, A. Organic amendments to avocado crops induce suppressiveness and influence the composition and activity of soil microbial communities. Appl. Environ. Microbiol. 2015, 81, 3405–3418. [Google Scholar] [CrossRef] [PubMed]
- Breitling, R.; Ceniceros, A.; Jankevics, A.; Takano, E. Metabolomics for secondary metabolite research. Metabolites 2013, 3, 1076–1083. [Google Scholar] [CrossRef]
- Ghorbanpour, M.; Omidvari, M.; Abbaszadeh-Dahaji, P.; Omidvar, R.; Kariman, K. Mechanisms underlying the protective effects of beneficial fungi against plant diseases. Biol. Control 2018, 117, 147–157. [Google Scholar] [CrossRef]
- Ghoneem, K.M.; Khalil, A.A.; Rashad, E.M.; Ahmed, M.I.; Mahmoud, M.S. Granular bioactive formulation of Trichoderma viride and Arbuscular mycorrhizal fungi for biological control of Cumin wilt disease. Egypt. J. Phytopathol. 2019, 47, 175–197. [Google Scholar] [CrossRef]
- da Silva, R.S.; Moutinho, B.L.; dos Santos, D.R.; Vasconcelo-Rodrigues, I.; Talamini, V.; Fernandes, M.F.; Fernandes, R.P. Using antagonistic soil bacteria and their cell-free filtrates to control the black rot pathogen Xanthomonas campestris pv. campestris. J. Phytopathol. 2018, 166, 494–501. [Google Scholar] [CrossRef]
- Moustaine, M.; El Kahkahi, R.; Benbouazza, A.; Benkirane, R. Potential of biological treatments for control of bacterial canker of tomato incited by Clavibacter michiganensis spp michiganensis in Morocco. EurAsian J. BioSciences 2019, 13, 1481–1488. [Google Scholar]
- Romano, N.; Lignola, G.; Brigante, M.; Bosso, L.; Chirico, G.B. Residual life and degradation assessment of wood elements used in soil bioengineering structures for slope protection. Ecol. Eng. 2016, 90, 498–509. [Google Scholar] [CrossRef]
- Sallam, N.; Ali, E.F.; Seleim, M.A.; Khalil Bagy, H.M. Endophytic fungi associated with soybean plants and their antagonistic activity against Rhizoctonia solani. Egypt. J. Biol. Pest Control 2021, 31, 1–9. [Google Scholar] [CrossRef]
- Suresh, S.; Mathiyazhalagan, N.; Selvam, R. Evaluation of bioagents and bactericides for controlling the Bacterial spot Disease in tomato. South Asian J. Eng. Technol. 2015, 1, 1–10. [Google Scholar]
- Gwa, V.; Ekefan, E. Fungal organisms isolated from rotted white yam (Dioscorea rotundata) tubers and antagonistic potential of Trichoderma harzianum against Colletotrichum species. Agric. Res. Tech. Open Access J. 2017, 10, 555787. [Google Scholar]
- Hang, N.T.T.; Oh, S.O.; Kim, G.H.; Hur, J.S.; Koh, Y.J. Bacillus subtilis S1-0210 as a biocontrol agent against Botrytis cinerea in strawberries. Plant Pathol. J. 2005, 21, 59–63. [Google Scholar] [CrossRef]
- Vitória, A.P.; Lea, P.J.; Azevedo, R.A. Antioxidant enzymes responses to cadmium in radish tissues. Phytochemistry 2001, 57, 701–710. [Google Scholar] [CrossRef] [PubMed]
- Mergawy, M.M.; Metwaly, H.A.; Shoeip, A.M. Evaluation of the efficacy of some bioagents accompanied with Bio-and Mineral Fertilizers in controlling early blight of tomato and improvement yield. Egypt. J. Phytopathol. 2022, 50, 31–50. [Google Scholar] [CrossRef]
- Lisker, N.; Cohen, L.; Chalutz, E.; Fuchs, Y. Fungal infections suppress ethylene-induced phenylalanine ammonia-lyase activity in grapefruits. Physiol. Plant Pathol. 1983, 22, 331–338. [Google Scholar] [CrossRef]
- Boller, T.; Gehri, A.; Mauch, F.; Vögeli, U. Chitinase in bean leaves: Induction by ethylene, purification, properties, and possible function. Planta 1983, 157, 22–31. [Google Scholar] [CrossRef]
- Legrand, M.; Kauffmann, S.; Geoffroy, P.; Fritig, B. Biological function of pathogenesis-related proteins: Four tobacco pathogenesis-related proteins are chitinases. Proc. Natl. Acad. Sci. USA 1987, 84, 6750–6754. [Google Scholar] [CrossRef]
- Reissig, J.L.; Strominger, J.L.; Leloir, L.F. A modified colorimetric method for the estimation of N-acetylamino sugars. J. Biol. Chem. 1955, 217, 959–966. [Google Scholar] [CrossRef]
- Boller, T.; Metraux, J. Extracellular localization of chitinase in cucumber. Physiol. Mol. Plant Pathol. 1988, 33, 11–16. [Google Scholar] [CrossRef]
- Snell, F.D.; Snell, C.T. Colorimetric Methods of Analysis; D. Van Nostrand Company Inc.: Princeton, NJ, USA; Toronto, ON, Canada; New York, NY, USA; London, UK, 1959; 606p. [Google Scholar]
- Fadeel, A. Assimilation of carbon dioxide by chlorophyllous roots. Physiol. Plant. 1963, 16, 870–888. [Google Scholar] [CrossRef]
- Ibrahim, S.; Abo-ELwafa, T. Alleviation harmful impacts of salinity using some antioxidants substances on Thompson seedless grapevines seedlings. J. Plant Prod. 2018, 9, 39–49. [Google Scholar] [CrossRef]
- Adhikari, P.; Adhikari, T.B.; Louws, F.J.; Panthee, D.R. Advances and challenges in bacterial spot resistance breeding in tomato (Solanum lycopersicum L.). Int. J. Mol. Sci. 2020, 21, 1734. [Google Scholar] [CrossRef] [PubMed]
- Peng, Y.; Li, S.J.; Yan, J.; Tang, Y.; Cheng, J.P.; Gao, A.J.; Yao, X.; Ruan, J.J.; Xu, B.L. Research progress on phytopathogenic fungi and their role as biocontrol agents. Front. Microbiol. 2021, 12, 670135. [Google Scholar] [CrossRef] [PubMed]
- Défago, G.; Haas, D. Pseudomonads as antagonists of soilborne plant pathogens: Modes of action and genetic analysis. In Soil Biochemistry; Routledge: London, UK, 2017; pp. 249–292. [Google Scholar]
- Bakker, P.; Peer, R.V.; Schippers, B. Specificity of siderophores and siderophore receptors and biocontrol by Pseudomonas spp. Biol. Control Soil-Borne Plant Pathogens 1990, 131–142. [Google Scholar]
- Chen, X.; Wang, Y.; Gao, Y.; Gao, T.; Zhang, D. Inhibitory abilities of Bacillus isolates and their culture filtrates against the gray mold caused by Botrytis cinerea on postharvest fruit. Plant Pathol. J. 2019, 35, 425. [Google Scholar] [CrossRef] [PubMed]
- Imran, M.; Abo-Elyousr, K.A.M.; Mousa, M.A.A.; Saad, M.M. Use of Trichoderma culture filtrates as a sustainable approach to mitigate early blight disease of tomato and their influence on plant biomarkers and antioxidants production. Front. Plant Sci. 2023, 14, 1192818. [Google Scholar] [CrossRef]
- Zhou, Y.; Yang, L.; Wang, J.; Guo, L.; Huang, J. Synergistic Effect between Trichoderma virens and Bacillus velezensis on the Control of Tomato Bacterial Wilt Disease. Horticulturae 2021, 7, 439. [Google Scholar] [CrossRef]
- Zhang, Y.; Callaway, E.M.; Jones, J.B.; Wilson, M. Visualisation of hrp gene expression in Xanthomonas euvesicatoria in the tomato phyllosphere. Eur. J. Plant Pathol. 2009, 124, 379–390. [Google Scholar] [CrossRef]
- Shafi, J.; Tian, H.; Ji, M. Bacillus species as versatile weapons for plant pathogens: A review. Biotechnol. Biotechnol. Equip. 2017, 31, 446–459. [Google Scholar] [CrossRef]
- Bardin, M.; Ajouz, S.; Comby, M.; Lopez-Ferber, M.; Graillot, B.; Siegwart, M.; Nicot, P.C. Is the efficacy of biological control against plant diseases likely to be more durable than that of chemical pesticides? Front. Plant Sci. 2015, 6, 566. [Google Scholar] [CrossRef]
- Khan, M.A.; Zhao, Y.; Korban, S.S. Molecular mechanisms of pathogenesis and resistance to the bacterial pathogen Erwinia amylovora, causal agent of fire blight disease in Rosaceae. Plant Mol. Biol. Report. 2012, 30, 247–260. [Google Scholar] [CrossRef]
- Aliye, N.; Fininsa, C.; Hiskias, Y. Evaluation of rhizosphere bacterial antagonists for their potential to bioprotect potato (Solanum tuberosum) against bacterial wilt (Ralstonia solanacearum). Biol. Control 2008, 47, 282–288. [Google Scholar] [CrossRef]
- Peypoux, F.; Bonmatin, J.; Wallach, J. Recent trends in the biochemistry of surfactin. Appl. Microbiol. Biotechnol. 1999, 51, 553–563. [Google Scholar] [CrossRef] [PubMed]
- Santoyo, G.; Orozco-Mosqueda, M.d.C.; Govindappa, M. Mechanisms of biocontrol and plant growth-promoting activity in soil bacterial species of Bacillus and Pseudomonas: A review. Biocontrol Sci. Technol. 2012, 22, 855–872. [Google Scholar] [CrossRef]
- Labuschagne, N.; Pretorius, T.; Idris, A. Plant growth promoting rhizobacteria as biocontrol agents against soil-borne plant diseases. Plant Growth Health Promot. Bact. 2011, 211–230. [Google Scholar]
- Fira, D.; Dimkić, I.; Berić, T.; Lozo, J.; Stanković, S. Biological control of plant pathogens by Bacillus species. J. Biotechnol. 2018, 285, 44–55. [Google Scholar] [CrossRef]
- Bacon, C.W.; Palencia, E.R.; Hinton, D.M. Abiotic and biotic plant stress-tolerant and beneficial secondary metabolites produced by endophytic Bacillus species. In Plant Microbes Symbiosis: Applied Facets; Springer: Berlin/Heidelberg, Germany, 2014; pp. 163–177. [Google Scholar]
- Glick, B.R.; Glick, B.R. Biocontrol of bacteria and fungi. Benef. Plant-Bact. Interact. 2020, 181–230. [Google Scholar]
- Rabbee, M.F.; Ali, M.S.; Choi, J.; Hwang, B.S.; Jeong, S.C.; Baek, K.-H. Bacillus velezensis: A valuable member of bioactive molecules within plant microbiomes. Molecules 2019, 24, 1046. [Google Scholar] [CrossRef]
- Pascual, J.; García-López, M.; Carmona, C.; Sousa, T.d.S.; de Pedro, N.; Cautain, B.; Martín, J.; Vicente, F.; Reyes, F.; Bills, G.F. Pseudomonas soli sp. nov., a novel producer of xantholysin congeners. Syst. Appl. Microbiol. 2014, 37, 412–416. [Google Scholar] [CrossRef]
- Cook, R.J.; Baker, K.F. The Nature and Practice of Biological Control of Plant Pathogens; American Phytopathological Society: St. Paul, MN, USA, 1983. [Google Scholar]
- Howell, C. Mechanisms employed by Trichoderma species in the biological control of plant diseases: The history and evolution of current concepts. Plant Dis. 2003, 87, 4–10. [Google Scholar] [CrossRef] [PubMed]
- Leelavathi, M.; Vani, L.; Reena, P. Antimicrobial activity of Trichoderma harzianum against bacteria and fungi. Int. J. Curr. Microbiol. Appl. Sci 2014, 3, 96–103. [Google Scholar]
- Naher, L.; Yusuf, U.K.; Ismail, A.; Hossain, K. Trichoderma spp.: A biocontrol agent for sustainable management of plant diseases. Pak. J. Bot 2014, 46, 1489–1493. [Google Scholar]
- Aznar, A.; Dellagi, A. New insights into the role of siderophores as triggers of plant immunity: What can we learn from animals? J. Exp. Bot. 2015, 66, 3001–3010. [Google Scholar] [CrossRef]
- Liu, K.; Garrett, C.; Fadamiro, H.; Kloepper, J.W. Induction of systemic resistance in Chinese cabbage against black rot by plant growth-promoting rhizobacteria. Biol. Control 2016, 99, 8–13. [Google Scholar] [CrossRef]
- Ons, L.; Bylemans, D.; Thevissen, K.; Cammue, B.P. Combining biocontrol agents with chemical fungicides for integrated plant fungal disease control. Microorganisms 2020, 8, 1930. [Google Scholar] [CrossRef] [PubMed]
- Scortichini, M. Sustainable management of diseases in horticulture: Conventional and new options. Horticulturae 2022, 8, 517. [Google Scholar] [CrossRef]
- Wei, L.; Wang, D.; Gupta, R.; Kim, S.T.; Wang, Y. A proteomics insight into advancements in the rice–microbe interaction. Plants 2023, 12, 1079. [Google Scholar] [CrossRef]
- Ajuna, H.B.; Lim, H.-I.; Moon, J.-H.; Won, S.-J.; Choub, V.; Choi, S.-I.; Yun, J.-Y.; Ahn, Y.S. The Prospect of Hydrolytic Enzymes from Bacillus Species in the Biological Control of Pests and Diseases in Forest and Fruit Tree Production. Int. J. Mol. Sci. 2023, 24, 16889. [Google Scholar] [CrossRef]
- Debois, D.; Jourdan, E.; Smargiasso, N.; Thonart, P.; De Pauw, E.; Ongena, M. Spatiotemporal monitoring of the antibiome secreted by Bacillus biofilms on plant roots using MALDI mass spectrometry imaging. Anal. Chem. 2014, 86, 4431–4438. [Google Scholar] [CrossRef]
- Morcillo, R.J.L.; Baroja-Fernández, E.; López-Serrano, L.; Leal-López, J.; Muñoz, F.J.; Bahaji, A.; Férez-Gómez, A.; Pozueta-Romero, J. Cell-free microbial culture filtrates as candidate biostimulants to enhance plant growth and yield and activate soil- and plant-associated beneficial microbiota. Front. Plant Sci. 2022, 13, 1040515. [Google Scholar] [CrossRef] [PubMed]
- Nithyapriya, S.; Lalitha, S.; Sayyed, R.Z.; Reddy, M.S.; Dailin, D.J.; El Enshasy, H.A.; Luh Suriani, N.; Herlambang, S. Production, Purification, and Characterization of Bacillibactin Siderophore of Bacillus subtilis and Its Application for Improvement in Plant Growth and Oil Content in Sesame. Sustainability 2021, 13, 5394. [Google Scholar] [CrossRef]
- Ansari, M.; Devi, B.M.; Sarkar, A.; Chattopadhyay, A.; Satnami, L.; Balu, P.; Choudhary, M.; Shahid, M.A.; Jailani, A.A.K. Microbial Exudates as Biostimulants: Role in Plant Growth Promotion and Stress Mitigation. J. Xenobiotics 2023, 13, 572–603. [Google Scholar] [CrossRef]
- Avdiushko, S.; Ye, X.; Kuc, J. Detection of several enzymatic activities in leaf prints of cucumber plants. Physiol. Mol. Plant Pathol. 1993, 42, 441–454. [Google Scholar] [CrossRef]
- Fan, S.; Tian, F.; Li, J.; Hutchins, W.; Chen, H.; Yang, F.; Yuan, X.; Cui, Z.; Yang, C.H.; He, C. Identification of phenolic compounds that suppress the virulence of Xanthomonas oryzae on rice via the type III secretion system. Mol. Plant Pathol. 2017, 18, 555–568. [Google Scholar] [CrossRef]
- Sharifi-Rad, J.; Quispe, C.; Zam, W.; Kumar, M.; Cardoso, S.M.; Pereira, O.R.; Ademiluyi, A.O.; Adeleke, O.; Moreira, A.C.; Živković, J. Phenolic bioactives as antiplatelet aggregation factors: The pivotal ingredients in maintaining cardiovascular health. Oxidative Med. Cell. Longev. 2021, 2021, 2195902. [Google Scholar] [CrossRef] [PubMed]
- Bassanezi, R.; Yamamoto, P.; Gimenes-Fernandes, N. Progresso dos sintomas de “morte súbita” em pomares de laranjeiras ‘Valência’e ‘Pêra’. Summa Phytopathol. 2002, 28, 23. [Google Scholar]
- Han, S.-W.; Choi, M.-S.; Lee, S.-H.; Hwang, D.-J.; Hwang, B.-K.; Heu, S.-G. Characterization of a novel necrotic response of Glycine max line’PI96188’to Xanthomonas axonopodis pv. glycines. Plant Pathol. J. 2007, 23, 193–202. [Google Scholar] [CrossRef]

| Pathogen | Bioagent | % Reduction | ||
|---|---|---|---|---|
| 25% | 50% | 100% | ||
| X. campestris pv. vesicatoria (Xcv1) | B. subtilis | 41.1 l | 56.3 gh | 71.8 a |
| P. fluorescens | 27.3 pqr | 54.5 h | 69.1 bc | |
| S. marcescens | 25.7 r | 36.6 m | 43.8 k | |
| X. euvesicatoria (Xe2) | B. subtilis | 31.6 n | 55.0 h | 63.4 f |
| P. fluorescens | 17.9 t | 42.0 kl | 63.4 f | |
| S. marcescens | 20.5 s | 28.6 pq | 36.7 m | |
| P. syringae pv. tomato (Pst1) | B. subtilis | 27.4 pqr | 64.1 f | 71.1 ab |
| P. fluorescens | 29.3 op | 58.3 g | 68.8 cd | |
| S. marcescens | 26.4 qr | 31.0 no | 47.1 j | |
| P. syringae pv. tomato (Pst2) | B. subtilis | 21.6 s | 51.0 i | 66.7 de |
| P. fluorescens | 14.2 u | 63.7 f | 65.1 ef | |
| S. marcescens | 21.8 s | 25.4 r | 43.3 k | |
| LSD | Bacteria | 2.84 | ||
| Bioagent | 1.96 | |||
| bacteria × bioagent | 1.81 | |||
| Pathogen | Bioagent | %Reduction | ||
|---|---|---|---|---|
| 25% | 50% | 100% | ||
| X. campestris pv. vesicatoria (Xcv1) | T. viride | 43.1 i | 52.9 g | 73.7 a |
| T. harzianum | 25.7 m | 30.4 kl | 59.3 e | |
| T. album | 20.3 n | 29.3 l | 41.9 i | |
| X. euvesicatoria (Xe2) | T. viride | 55.4 f | 64.5 d | 71.0 b |
| T. harzianum | 21.6 n | 32.5 k | 46.3 h | |
| T. album | 16.9 o | 28.6 l | 36.6 j | |
| P. syringae pv. tomato (Pst1) | T. viride | 46.6 h | 51.2 g | 68.0 c |
| T. harzianum | 30.4 kl | 46.8 h | 55.9 f | |
| T. album | 28.9 l | 37.7 j | 42.5 i | |
| P. syringae pv. tomato (Pst2) | T. viride | 28.9 l | 45.6 h | 59.6 e |
| T. harzianum | 17.2 o | 24.6 m | 43.1 i | |
| T. album | 17.3 o | 20.1 n | 31.9 k | |
| LSD | Bacteria | 3.34 | ||
| Bioagent | 2.31 | |||
| bacteria × bioagent | 2.13 | |||
| Pathogen | Bioagent | %Reduction | |
|---|---|---|---|
| DI% | DS% | ||
| X. campestris pv. vesicatoria (Xcv1) | B. subtilis | 56.9 gh | 65.4 j |
| P. fluorescens | 43.0 b–f | 46.5 c–g | |
| T. viride | 53.8 fgh | 58.3 hi | |
| T. harzianum | 48.8 def | 55.0 f–i | |
| T. album | 43.1 b | 46.8 ghi | |
| Infected | 100.0 a | 90.5 ab | |
| Healthy | 0.0 i | 0.0 k | |
| X. euvesicatoria (Xe2) | B. subtilis | 54.8 d–h | 60.0 hij |
| P. fluorescens | 39.7 bc | 43.6 cd | |
| T. viride | 50.8 d–g | 52.3 e–i | |
| T. harzianum | 45.4 bcde | 52.7 e–i | |
| T. album | 36.7 bcd | 41.4 d–h | |
| Infected | 100.0 a | 95.4 a | |
| Healthy | 0.0 i | 0.0 k | |
| P. syringae pv. tomato (Pst1) | B.subtilis | 41.7 fgh | 56.6 ij |
| P. fluorescens | 34.9 c–f | 39.5 c–f | |
| T. viride | 47.7 h | 51.1 ghi | |
| T. harzianum | 43.5 fgh | 53.3 hi | |
| T. album | 40.7 e–h | 44.8 g–h | |
| Infected | 95.0 a | 80.0 b | |
| Healthy | 0.0 i | 0.0 k | |
| P. syringae pv. tomato (Pst2) | B. subtilis | 34.9 bcde | 51.5 d–h |
| P. fluorescens | 33.4 bcd | 37.1 c | |
| T. viride | 39.5 b–f | 41.5 cd | |
| T. harzianum | 50.0 def | 40.5 d–h | |
| T. album | 38.4 b–f | 39.8 cd | |
| Infected | 100.0a | 85.5 ab | |
| Healthy | 0.0 i | 0.0 k | |
| LSD | Bacteria | 4.28 | 3.99 |
| Bioagent | 5.67 | 5.27 | |
| bacteria × bioagent | 11.33 | 10.55 | |
| Bioagent | Pathogen | Free Phenol | Bound Phenol | Total Phenol |
|---|---|---|---|---|
| Infected control | Healthy control | 1.25 o | 0.50 v | 1.75 s |
| X.campestris pv. vesicatoria (Xcv1) | 1.55 gh | 0.68 s | 2.23 mn | |
| X. euvesicatoria (Xe2) | 1.51 ij | 0.65 tu | 2.17 o | |
| P. syringae pv. tomato (Pst1) | 1.52 hij | 0.66 st | 2.18 no | |
| P. syringae pv. tomato (Pst2) | 1.51 ijk | 0.66 tu | 2.16 o | |
| B. subtilis | Healthy control | 1.25 no | 0.64 u | 1.90 r |
| X. campestris pv. vesicatoria (Xcv1) | 1.46 l | 0.78 o | 2.24 m | |
| X. euvesicatoria (Xe2) | 1.48 kl | 0.80 n | 2.27 lm | |
| P. syringae pv. tomato (Pst1) | 1.49 jkl | 0.81 mn | 2.30 kl | |
| P. syringae pv. tomato (Pst2) | 1.50 ijk | 0.82 m | 2.32 jk | |
| P. fluorescens | Healthy control | 1.27 mn | 0.70 r | 1.98 q |
| X. campestris pv. vesicatoria (Xcv1) | 1.55 gh | 0.88 i | 2.43 gh | |
| X. euvesicatoria (Xe2) | 1.55 fgh | 0.89 hi | 2.44 g | |
| P. syringae pv. tomato (Pst1) | 1.57 efg | 0.90 gh | 2.47 fg | |
| P. syringae pv. tomato (Pst2) | 1.58 efg | 0.91 g | 2.49 ef | |
| T. viride | Healthy control | 1.26 no | 0.66 st | 1.92 r |
| X. campestris pv. vesicatoria (Xcv1) | 1.51 ij | 0.84 kl | 2.35 ij | |
| X. euvesicatoria (Xe1) | 1.50 ijk | 0.84 k | 2.34 ijk | |
| P. syringae pv. tomato (Pst1) | 1.53 hi | 0.86 j | 2.38 hi | |
| P. syringae pv. tomato (Pst2) | 1.53 hij | 0.86 j | 2.38 i | |
| T. harzianum | Healthy control | 1.31 m | 0.73 q | 2.04 cd |
| X. campestris pv. vesicatoria (Xcv1) | 1.59 de | 0.93 f | 2.52 de | |
| X. euvesicatoria (Xe2) | 1.59 def | 0.93 df | 2.52 de | |
| P. syringae pv. tomato (Pst1) | 1.60 b-e | 0.95 de | 2.55 cd | |
| P. syringae pv. tomato (Pst2) | 1.60 cde | 0.95 d | 2.55 cd | |
| T. album | Healthy control | 1.33 m | 0.76 p | 2.09 s |
| X. campestris pv. vesicatoria (Xcv1) | 1.61 bcd | 0.97 c | 2.58 bc | |
| X. euvesicatoria (Xe2) | 1.64 ab | 0.99 b | 2.62 ab | |
| P. syringae pv. tomato (Pst1) | 1.63 abc | 0.99 b | 2.62 ab | |
| P. syringae pv. tomato (Pst2) | 1.66 a | 1.01 a | 2.66 a | |
| LSD | Bacteria | 0.01 | 6.25 | 0.01 |
| Bioagent | 0.01 | 6.51 | 0.02 | |
| bacteria × bioagent | 0.04 | 0.02 | 0.05 |
| Bioagent | Pathogen | Chitinase | Polyphenol Oxidase | Peroxidase |
|---|---|---|---|---|
| Infected control | Healthy control | 0.06 t | 30.63 b | 49.0 n–q |
| X. campestris pv. vesicatoria (Xcv1) | 0.07 st | 32.39 c | 51.8 pq | |
| X. euvesicatoria (Xe2) | 0.08 rs | 34.52 ab | 55.2 l–p | |
| P. syringae pv. tomato (Pst1) | 0.08 r | 35.21 d | 56.3 q | |
| P. syringae pv. tomato (Pst2) | 0.09 q | 39.54 a | 63.3 l–p | |
| B. subtilis | Healthy control | 0.21 mn | 0.25 abc | 64.5 n–q |
| X. campestris pv. vesicatoria (Xcv1) | 0.31 j | 0.31 e | 65.8 b–f | |
| X. euvesicatoria (Xe2) | 0.35 h | 0.35 e | 66.5 ab | |
| P. syringae pv. tomato (Pst1) | 0.46 cd | 0.46 e | 71.8 g–k | |
| P. syringae pv. tomato (Pst2) | 0.51 a | 0.51 e | 78.1 abc | |
| P.fluorescens | Healthy control | 0.24 o | 0.24 abc | 60.4 n–q |
| X. campestris pv. vesicatoria (Xcv1) | 0.28 j | 0.28 e | 61.8 f–j | |
| X. euvesicatoria (Xe2) | 0.31 i | 0.31 e | 62.5 b–f | |
| P. syringae pv. tomato (Pst1) | 0.45 e | 0.45 e | 67.4 k–o | |
| P. syringae pv. tomato (Pst2) | 0.45 de | 0.45 e | 73.2 c–g | |
| T.viride | Healthy control | 0.28 k | 0.28 abc | 62.6 n–q |
| X. campestris pv. vesicatoria (Xcv1) | 0.30 h | 0.30 e | 63.6 d–h | |
| X. euvesicatoria (Xe2) | 0.46 bc | 0.46 e | 64.6 a–d | |
| P. syringae pv. tomato (Pst1) | 0.355 h | 0.35 e | 69.7 l–m | |
| P. syringae pv. tomato (Pst2) | 0.47 b | 0.47 e | 75.5 a–e | |
| T. harzianum | Healthy control | 0.25 n | 0.25 abc | 58.4 n–q |
| X. campestris pv. vesicatoria (Xcv1) | 0.26 lm | 0.26 e | 59.3 h–l | |
| X. euvesicatoria (Xe2) | 0.26 l | 0.26 e | 60.1 e–h | |
| P. syringae pv. tomato (Pst1) | 0.44 f | 0.44 e | 64.7 m–p | |
| P. syringae pv. tomato (Pst2) | 0.45 e | 0.45 e | 71.0 g e–i | |
| T. album | Healthy control | 0.21 p | 0.21 abc | 56.2 n–q |
| X. campestris pv. vesicatoria (Xcv1) | 0.24 o | 0.24 e | 57.7 j–n | |
| X. euvesicatoria (Xe2) | 0.26 l | 0.26 e | 58.3 g–j | |
| P. syringae pv. tomato (Pst1) | 0.41 g | 0.41 e | 62.8 o–q | |
| P. syringae pv. tomato (Pst2) | 0.43 f | 0.43 e | 68.4 jg–k | |
| LSD | bacteria | 2.47 | 0.27 | 1.33 |
| bioagent | 2.99 | 0.80 | 1.14 | |
| bacteria × bioagent | 8.27 | 0.90 | 4.47 |
| Bioagent | Pathogen | Chlorophyll a Mg/g Leaves | Chlorophyll b Mg/g Leaves | Carotenoids Mg/g Leaves |
|---|---|---|---|---|
| Infected control | Healthy control | 1.51 j | 0.80 c–g | 1.07 h |
| X. campestris pv. vesicatoria (Xcv1) | 1.62 hij | 0.85 c–g | 1.15 fgh | |
| X. euvesicatoria (Xe2) | 1.61 hij | 0.85 d–g | 1.15 fgh | |
| P. syringae pv. tomato (Pst1) | 1.57 hij | 0.85 fg | 1.14 fgh | |
| P. syringae pv. tomato (Pst2) | 1.56 j | 0.81 fg | 1.13 gh | |
| B. subtilis | Healthy control | 1.62 fgh | 0.89 b–g | 1.21 def |
| X. campestris pv. vesicatoria (Xcv1) | 2.05 a | 1.06 a | 1.43 a | |
| X. euvesicatoria (Xe2) | 2.05 a | 1.05 ab | 1.42 a | |
| P. syringae pv. tomato (Pst1) | 2.04 ab | 1.05 ab | 1.42 a | |
| P. syringae pv. tomato (Pst2) | 1.99 abc | 1.04 abc | 1.41 a | |
| P. fluorescens | Healthy control | 1.68 ghi | 0.88 b–g | 1.19 def |
| X. campestris pv. vesicatoria (Xcv1) | 1.96 a–d | 1.03 a–d | 1.37 ab | |
| X. euvesicatoria (Xe2) | 1.95 a–d | 1.02 a–d | 1.36 ab | |
| P. syringae pv. tomato (Pst1) | 1.95 a–d | 1.02 a–d | 1.37 ab | |
| P. syringae pv. tomato (Pst2) | 1.95 a–d | 1.02 a–e | 1.36 ab | |
| T. virdi | Healthy control | 1.69 fgh | 0.88 b–g | 1.20 def |
| X. campestris pv. vesicatoria (Xcv1) | 1.98 abc | 1.04 abc | 1.40 a | |
| X. euvesicatoria (Xe2) | 1.97 abc | 1.03 a–d | 1.40 a | |
| P. syringae pv. tomato (Pst1) | 1.97 abc | 1.03 a–d | 1.38 a | |
| P. syringae pv. tomato (Pst2) | 1.97 abc | 1.03 a–d | 1.37 a | |
| T. harzianum | Healthy control | 1.68 hij | 0.87 efg | 1.19 e–h |
| X. campestris pv. vesicatoria (Xcv1) | 1.93 a–e | 1.02 a–e | 1.36 ab | |
| X. euvesicatoria (Xe2) | 1.93 a–d | 1.02 a–d | 1.35 ab | |
| P. syringae pv. tomato (Pst1) | 1.93a–d | 1.01 a–e | 1.35 ab | |
| P. syringae pv. tomato (Pst2) | 1.93 efg | 0.99 a–g | 1.35 cde | |
| T. album | Healthy control | 1.67 hij | 0.87 efg | 1.19 fgh |
| X. campestris pv. vesicatoria (Xcv1) | 1.92b–e | 0.99 a–e | 1.35 abc | |
| X. euvesicatoria (Xe2) | 1.92 b–e | 0.99 a–f | 1.34 abc | |
| P. syringae pv. tomato (Pst1) | 1.91 cde | 0.99 a–d | 1.33 ab | |
| P. syringae pv. tomato (Pst2) | 1.90 def | 0.99 a–g | 1.33 bcd | |
| LSD | bacteria | 0.05 | 0.03 | 0.04 |
| bioagent | 0.07 | 0.17 | 0.06 | |
| bacteria × bioagent | 0.13 | 0.06 | 0.09 |
Disclaimer/Publisher’s Note: The statements, opinions and data contained in all publications are solely those of the individual author(s) and contributor(s) and not of MDPI and/or the editor(s). MDPI and/or the editor(s) disclaim responsibility for any injury to people or property resulting from any ideas, methods, instructions or products referred to in the content. |
© 2024 by the authors. Licensee MDPI, Basel, Switzerland. This article is an open access article distributed under the terms and conditions of the Creative Commons Attribution (CC BY) license (https://creativecommons.org/licenses/by/4.0/).
Share and Cite
Akila, A.H.; Ali, M.A.S.; Khairy, A.M.; Elnahal, A.S.M.; Alfassam, H.E.; Rudayni, H.A.; Jaber, F.A.; Tohamy, M.R.A. Biological Control of Tomato Bacterial Leaf Spots and Its Impact on Some Antioxidant Enzymes, Phenolic Compounds, and Pigment Content. Biology 2024, 13, 369. https://doi.org/10.3390/biology13060369
Akila AH, Ali MAS, Khairy AM, Elnahal ASM, Alfassam HE, Rudayni HA, Jaber FA, Tohamy MRA. Biological Control of Tomato Bacterial Leaf Spots and Its Impact on Some Antioxidant Enzymes, Phenolic Compounds, and Pigment Content. Biology. 2024; 13(6):369. https://doi.org/10.3390/biology13060369
Chicago/Turabian StyleAkila, Asmaa H., Mohamed A. S. Ali, Ahmed M. Khairy, Ahmed S. M. Elnahal, Haifa E. Alfassam, Hassan A. Rudayni, Fatima A. Jaber, and Mohamed R. A. Tohamy. 2024. "Biological Control of Tomato Bacterial Leaf Spots and Its Impact on Some Antioxidant Enzymes, Phenolic Compounds, and Pigment Content" Biology 13, no. 6: 369. https://doi.org/10.3390/biology13060369
APA StyleAkila, A. H., Ali, M. A. S., Khairy, A. M., Elnahal, A. S. M., Alfassam, H. E., Rudayni, H. A., Jaber, F. A., & Tohamy, M. R. A. (2024). Biological Control of Tomato Bacterial Leaf Spots and Its Impact on Some Antioxidant Enzymes, Phenolic Compounds, and Pigment Content. Biology, 13(6), 369. https://doi.org/10.3390/biology13060369







